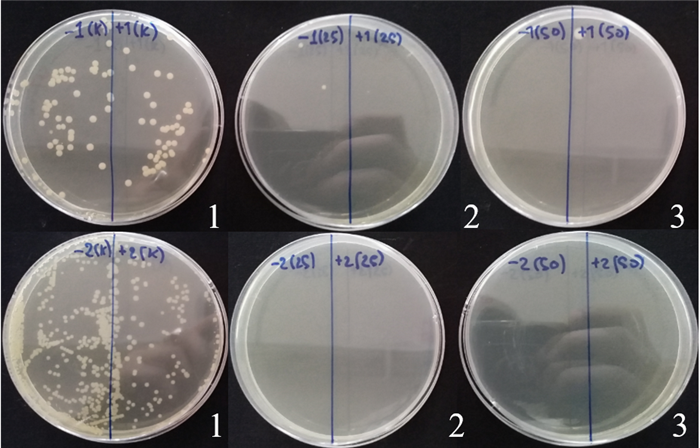

Биологически активные добавки и биостимуляторы на основе микроводорослей для применения в аграрной и пищевой промышленности
20.11.2021Наименование проекта: Биологически активные добавки и биостимуляторы на основе микроводорослей для применения в аграрной и пищевой промышленности
Научный руководитель проекта: д.б.н., профессор, академик НАН РК Заядан Б.К.
Цель проекта - Разработать технологию получения биологически активных добавок и биостимуляторов для применения в аграрной и пищевой промышленности на основе производственно-ценных штаммов микроводорослей.
НОУ-ХАУ
Микроводоросли являясь источником множества ценных соединений, представляют большой интерес в аграрной, медицинской, косметической и пищевой промышленностях как новые и безопасные источники биологически активных препаратов. Они характеризуются иммуномодулирующим, антиоксидантным, антиметастатическим действием, способным тормозить развитие злокачественных образований в организме человека и животных. Биологически активные добавки на основе данных организмов представляют собой натуральные, доступные по цене, экологически безопасные профилактические биопрепараты, не вызывающие побочных реакций, не обладающие противопоказаниями к применению.
Актуальность и новизна
Микроводоросли содержат до 50-70% легкоусвояемого белка (к сравнению до 50% в мясе и 15-17% в пшенице), до 30% липидов, более 40% глицерина, до 8-14% пигментов, в том числе каротина и довольно высокая концентрация витаминов B1, B2, B3, B6, B12, E, K, D по сравнению с другими растениями или животными. Пищевые микроводоросли являются хорошим источником белков, незаменимых аминокислот, фитостеринов, углеводов, витаминов, характеризуются уникальным сочетанием биологически активных соединений, полиненасыщенных жирных кислот с высоким содержанием гамма-линоленовой кислоты и многими другими полезными для здоровья соединениями. Они, обладая уникальными биохимическими и физиологическими свойствами, являются источниками таких пигментов, как хлорофилл, альфа- и бета- каротин, ликопин, лютеин, зеаксантин и астаксантин, фикоцианин, которые обладая антиоксидантными и противоопухолевыми свойствами используются в медицинской, пищевой, нутрицевтической и косметической промышленности.
Микроводоросли хорошо известны своими разнообразными биологическими действиями, такими как антибактериальные, противогрибковые, цитотоксические, иммуносупрессивные, противоаллергические свойства и противовирусная активность, что тоже предопределяют их большие возможности в медицине и фармокологии, при получении биологически активных добавок и биостимуляторов для укрепления иммунитета.
Практическая значимость
Большое количество солнечных дней и выгодное географическое расположение нашей Республики Казахстан, относительная простота культивирования микроводорослей для получения ее биомассы создают предпосылки для развития производств по получению биологически активных добавок (БАД) и биостимуляторов на их основе. Показано, что применение микроводорослей в животноводстве в качестве источника белка, витаминов и других физиологически активных веществ повышает устойчивость животных к различным заболеваниям, в первую очередь, связанным с авитаминозом, ускоряет обменные процессы, и таким образом способствуют повышению объема и качества товарной продукции. Кроме того необходимо отметить о возможностях создания новых рабочих мест на предприятиях по производству биопрепаратов, биокормов и пищевых биодабавок.
Ожидаемые результаты
Будет разработана технология массового культивирования производственно - ценных штаммов микроводорослей для получения биологически активных веществ из продуцентов – активных штаммов микроводорослей.
Будет разработана технология получения новых биологически активных добавок и биостимуляторов на основе производственно - ценных штаммов микроводорослей и изучены их биологические свойства.
Будет разработана рецептура и товарные формы новых биологически активных добавок и биостимуляторов на основе биомассы производственно - ценных штаммов микроводорослей.
Объект внедрения
Биологически активные добавки и биостимуляторы на основе биомассы микроводорослей, содержащие незаменимые аминокислоты, витамины группы В, С, Д, провитамин А, полиненасыщенные жирные кислоты, углеводы, полисахариды и обладающие высокой биодоступностью и большим потенциалом в пищевой, терапевтической промышленности и животноводстве.
Перспективы внедрения
Технология получения биодобавок на основе микроводорослей имеет большие реальные перспективы внедрения ее в производство. Перспективность настоящего проекта определяется не только экономической рентабельностью, но и возможностью получения новых, экологически чистых, уникальных биопрепаратов на основе микроводорослей. Поэтому, вопросы промышленного производства микроводорослей привлекают всё большее внимание исследователей и промышленных фирм. Так, обладая высокой продуктивностью, эти объекты одновременно являются продуцентами новых ценных продуктов, которые находят широкое применение в пищевой промышленности (как биологически активные добавки) и в аграрном секторе, в частности в животноводстве, птицеводстве, рыбной хозяйстве (биологически активные кормовые добавки). При этом, необходимо учитывать, что получение биологически активных добавок на основе микроводорослей может быть экономически выгодным, поскольку не требует дорогостоящего оборудования и питательных сред для их культивирования.
Потребители
Агропромышленный сектор (птицефабрики, свиноводство, животноводческие фермы, аквакультура), пищевая промышленность, фармакология и медицина.
Конкурентоспособность
Конкурентоспособность данного проекта определяется вышеперечисленными уникальными свойствами микроводорослей и преимуществами технологии их культивирования (дешевая питательная среда, солнце, не дорогое оборудование). Предлагаемый проект оригинален, пока аналогов в Республике нет. Биотехнология микроводорослей хорошо разработана в США, Японии, Индии, России, Китае, Чехии и других странах мира. В Казахстане предприятий по производству биопрепаратов на основе микроводорослей и других фототрофных микроорганизмов нет. Проект имеет хорошую коммерческую перспективу и большой потенциал коммерциализации.